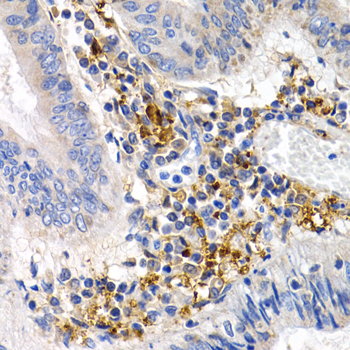

For quotations, please use our online quotation form, and you may also contact us by
service@kendallscientific.com
+1-888.733.6849 (Toll-free)
+1-617.299.7367 (Int’l))
+1-888.733.6849
Our customer service representatives are available 24 hours, Monday through Friday to assist you.| Reactivity | Human Mouse Rat |
| Tested applications | WB IHC |
| Recommended Dilution | WB 1:500 - 1:2000 IHC 1:50 - 1:200 |
| Calculated MW | 55kDa |
| Observed MW | Refer to figures |
| Immunogen | Recombinant protein of human GDF5 |
| Storage Buffer | Store at -20℃. Avoid freeze / thaw cycles. Buffer: PBS with 0.02% sodium azide, 50% glycerol, pH7.3. |
| Synonym | OS5; LAP4; BDA1C; BMP14; CDMP1; LAP-4; SYM1B; SYNS2; BMP-14; |

Western blot analysis of extracts of various cell lines, using GDF5 antibody.

Immunohistochemistry of paraffin-embedded human normal breast using GDF5 antibody at dilution of 1:200 (400x lens).
Immunohistochemistry of paraffin-embedded human colon cancer using GDF5 antibody at dilution of 1:200 (400x lens).
The protein encoded by this gene is a member of the bone morphogenetic protein (BMP) family and the TGF-beta superfamily. This group of proteins is characterized by a polybasic proteolytic processing site which is cleaved to produce a mature protein containing seven conserved cysteine residues. The members of this family are regulators of cell growth and differentiation in both embryonic and adult tissues. Mutations in this gene are associated with acromesomelic dysplasia, Hunter-Thompson type; brachydactyly, type C; and chondrodysplasia, Grebe type. These associations confirm that the gene product plays a role in skeletal development.
N/A